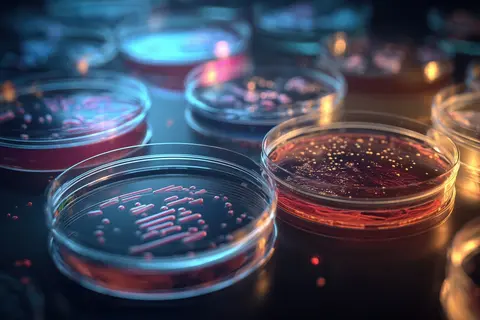
Boîtes de pétri en laboratoire

Votre recherche
2640 résultats trouvés
Dans le cadre du sommet One Health qui se tenait à Lyon jusqu’au 7 avril, le ministère de l’Agriculture a annoncé le lancement de l’appel à projets 2026 Écoantibio 3. Les candidatures sont ouvertes jusqu’au 1er juin.

À l’occasion de son assemblée générale, l’organisation sanitaire OS Porc Bretagne avait choisi de mieux comprendre le sanglier et voir toutes les mesures de biosécurité pouvant être mises en place au sein des élevages porcins.


